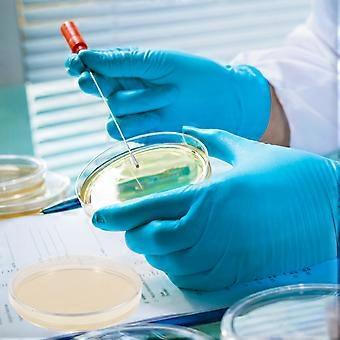

10pcs Agar Plates Portable Prepoured Agar Petri Dishes Science Fair Projects Supplies
- 브랜드: Unbranded

10pcs Agar Plates Portable Prepoured Agar Petri Dishes Science Fair Projects Supplies
- 브랜드: Unbranded
| 희망소매가격: | |
| 가격: | |
| 절약 금액: | ₩68,200 (64%) |
재고 있음
다음의 결제 방식을 사용하실 수 있습니다
설명
- 브랜드: Unbranded
- 카테고리: 연구
-
색상: Light Yellow
-
크기: 9.00X9.00X1.00CM
- Fruugo ID: 367076677-794667413
- EAN: 5461978001119
제품 안전 정보
아래에 설명된 이 제품과 관련된 제품 안전 정보를 참조하십시오.
以下の情報は、この製品を販売する独立したサードパーティ小売業者によって提供されています。
제품 안전 라벨

배송 및 반품
2일 이내에 발송됨
-
STANDARD: 무료 - 배달 사이 목 23 10월 2025–목 30 10월 2025 - 무료
중국에서 발송.
당사는 귀하께서 주문하신 제품이 주문 명세에 따라 빠짐없이 배송되도록 온 힘을 기울이고 있습니다. 다만, 주문하신 것과 다른 상품이 배송되거나 빠진 상품이 있는 경우, 또는 주문 내용에 만족할 수 없는 다른 이유가 있는 경우에는 주문 전체나 주문에 포함된 일부 제품을 반품하시고 해당 상품에 대해 전액 환불받으실 수 있습니다. 전체 반품 정책 보기
製品コンプライアンスの詳細
以下に概説されているこの製品に固有のコンプライアンス情報を参照してください。
以下の情報は、この製品を販売する独立したサードパーティ小売業者によって提供されています。
제조사:
다음 정보는 Fruugo에서 판매되는 관련 상품의 제조사 연락처입니다.
- Shen Zhen Mi Di Mi Ke Ji You Xian Gong Si
- Shen Zhen Mi Di Mi Ke Ji You Xian Gong Si
- A10B2, 1st Floor, ASEAN Building, No. 690 Minzhi Avenue, Xinniu Community, Minzhi Street, Longhua District, Shenzhen City
- Shenzhen
- CN
- 518000
- crassify@163.com
- 13502850154
EU 내 책임자:
다음 정보는 EU 내 책임자 연락처입니다. 책임자는 유럽 연합에서 판매되는 관련 상품에 대한 준수 의무에 책임을 지는 EU에 기반을 둔 지정 경제 주체를 말합니다.
- EC REP SERVICES SL
- EC REP SERVICES SL
- Calle Gran Via 49, 7 Dch.
- Madrid
- ES
- 28013
- ecrepservice@hotmail.com
- 0034 910 5631 02